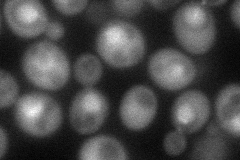
YBR160W
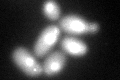
YBR160W
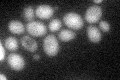
YBR160W

View description
Catalytic subunit of the main cell cycle cyclin-dependent kinase (CDK); alternately associates with G1 cyclins (CLNs) and G2/M cyclins (CLBs) which direct the CDK to specific substrates
Localization:
Intensity:
Fold change:
Significance:
-
C’ GFP library in SD

nucleus49.71 -
N' NOP1pr-GFP in SD
nucleus76.4636 -
N' TEF2pr-mCherry in SD

missing0 -
N' NATIVEpr-GFP in SD

missing0 -
N' TEF2pr-VC and Cyto-VN in SD

#N/A0 -
C’ GFP library in SD+DTT
nucleus64.551.29No -
C’ GFP library in SD+H2O2

nucleus58.051.16No -
C’ GFP library in Starvation Media
nucleus53.161.06No -
C’ GFP library on the background of Pup2-DaMP

nucleus -
C’ GFP library on the background of CCT mutant

nucleus48.63330.978157No
